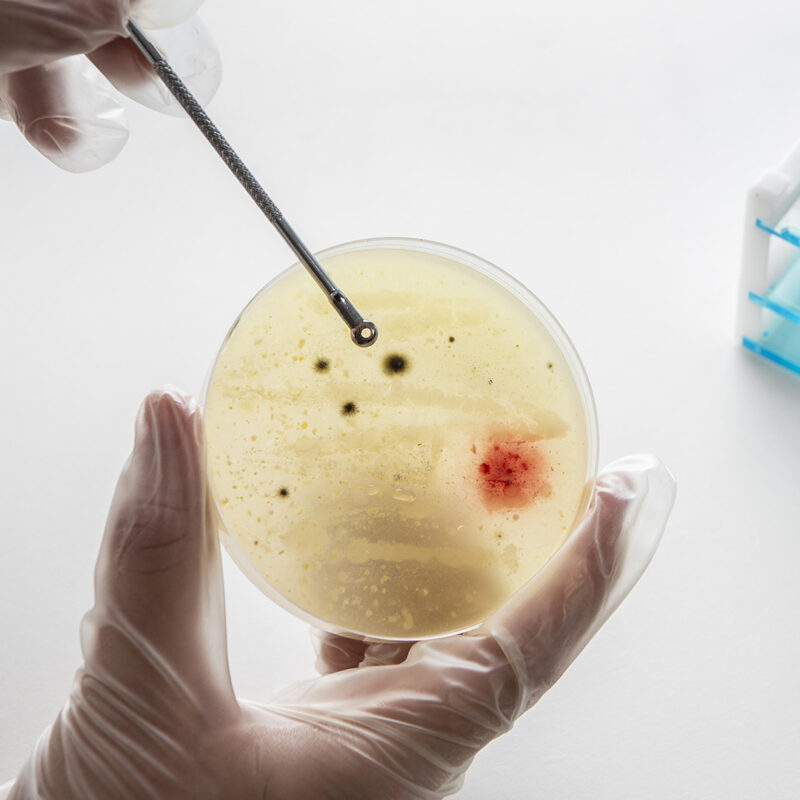

Microbiology / Virology
A comprehensive and relevant range of viral infections and diseases can be detected and monitored through our Virology Laboratory and services. Serology and molecular techniques are the mainstay of tests utilised in this department. A hub and spoke approach offers relevant molecular testing in the periphery (close to the patient) and centralised testing for certain other e.g. HIV resistance testing. Syndromic testing through means of molecular techniques, offered centrally and in the periphery, provides cost effective detection of a wide range of bacterial and viral disease in a short turn-around time.